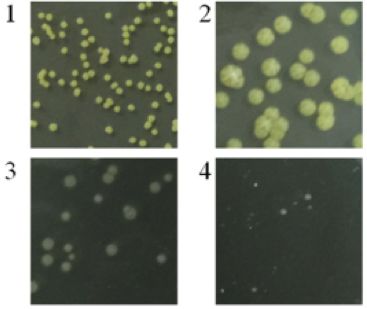

回顧2018,百邁客轉錄調控項目文章收獲頗豐:據不完全統計,已突破百篇,累積影響因子300+,涉及轉錄組、全轉錄組、非編碼RNA、全長(cháng)轉錄組、蛋白組、代謝組、降解組和原核轉錄組等。本次項目文章分享中,我們一起走進(jìn)微小生物世界,去看一看里面的大乾坤~
中文題目:在鹽刺激下對耐鹽擬諾卡氏菌YIM 90087T進(jìn)行轉錄組學(xué)和四氫嘧啶分析
英文題目:Transcriptomic and Ectoine Analysis of HalotolerantNocardiopsis gilva?YIM 90087T?Under Salt Stress
發(fā)表雜志:Frontiers in Microbiology
影響因子:4.019
發(fā)表時(shí)間:2018.03
研究背景
材料方法
試驗內容:
1、使用不同鹽濃度(0~15%)處理,觀(guān)察N.gilva?YIM 90087T的形態(tài)學(xué)變化、增殖、四氫嘧啶及羥基四氫嘧啶檢測,進(jìn)行表型測定
2、提取中期對數期YIM 90087T菌體RNA,進(jìn)行轉錄組測序
測序平臺:北京百邁客生物科技有限公司?Illumina Hiseq
研究結果
1、鹽含量對N. gilva?YIM 90087T的形態(tài)學(xué)和增殖情況影響
隨著(zhù)鹽濃度的增高,菌落顏色由黃色變?yōu)榘咨?,且?%的NaCl鹽溶液中生長(cháng)最佳,鹽濃度高于或低于該濃度,其生長(cháng)速度均會(huì )下降。

圖1、菌體表型觀(guān)察及生長(cháng)曲線(xiàn)
2、差異表達分析
對菌種進(jìn)行二代測序,篩選FDR<0.01,Fold Change≥2的基因為差異表達基因,并使用COG、GO、KEGG、Swissport和NR數據庫進(jìn)行注釋分析。通過(guò)COG分類(lèi),共獲得25個(gè)COG組別,其中氨基酸轉運和代謝、碳水化合物轉運和代謝是其主要組分。DEGs被分布在34個(gè)GO term里,其中包括細胞組分、分子功能和生物過(guò)程三大類(lèi)。與此同時(shí),三個(gè)比較組(5%/0%, 10%/0%和15%/0%)差異表達基因分別富集到77、32和90條KEGG通路中,其中ABC轉運受體,甘氨酸、絲氨酸和蘇氨酸代謝在鹽刺激下扮演相當重要的角色。尤其在最大耐受度的NaCl鹽環(huán)境里,參與ABC轉運受體通路的四氫嘧啶和羥基四氫嘧啶基因、甜菜堿基因和四氫嘧啶和羥基四氫嘧啶合成基因表達量都顯著(zhù)提高。

圖2、三個(gè)比較組的(5%/0%, 10%/0%和15%/0%)COG注釋
3、N. gilva?YIM 90087T菌種ect基因集的遺傳組成
對四氫嘧啶和羥基四氫嘧啶合成基因ectABCD進(jìn)行種屬分析。其中在18個(gè)擬諾卡氏菌系中存在2個(gè)常見(jiàn)的ectABCD基因簇類(lèi)型。ectABC屬于一個(gè)基因簇,而ectD則位于基因組的其他位置(type A, 15 strains),又或者ectABCD歸屬于相同的基因簇(type B, 3 strains)。此外,在N. potens?DSM 45234和N.prasina?DSM 43845菌系中發(fā)現至少一個(gè)ectAB或ectD基因。然而,在N.gilva?YIM 90087T中,基因簇類(lèi)型卻與其他菌系顯著(zhù)不同。ectA基因完全與ectBCD基因簇分開(kāi),且ehuABCD(四氫嘧啶和羥基四氫嘧啶ABC轉運受體基因)位于ectD基因的下游。

圖3、四氫嘧啶和羥基四氫嘧啶合成基因基因簇
4、參與四氫嘧啶和羥基四氫嘧啶合成和轉運基因的表達情況
對不同鹽環(huán)境下的參與四氫嘧啶和羥基四氫嘧啶合成和轉運基因的表達情況進(jìn)行分析,發(fā)現隨著(zhù)鹽濃度的升高,參與四氫嘧啶合成的基因有不同程度的上調,尤其在15%的鹽濃度中最顯著(zhù)。與其他基因不同的是,ectD基因從5%到10%和10%到15%鹽濃度下出現兩次上調。在N. gilva?YIM 90087T中發(fā)現有兩個(gè)特殊的ABC受體基因(ehuABCD和?proXWV)參與四氫嘧啶的轉運,并隨著(zhù)鹽濃度的升高而發(fā)生變化。ehuABCD表達情況與鹽濃度在大于5%以上時(shí)成正相關(guān),而proXWV的表達量變化在耐受鹽濃度環(huán)境中無(wú)變化。有趣的是,ehuABCD和proXWV基因在最大耐受鹽濃度中表達活性最高。
表1、在不同鹽濃度刺激下四氫嘧啶和羥基四氫嘧啶合成與轉運基因的表達情況

5、N. gilva?YIM 90087T中四氫嘧啶和羥基四氫嘧啶的累積
使用HPLC對四氫嘧啶和羥基四氫嘧啶含量進(jìn)行檢測,結果發(fā)現,胞內這兩種物質(zhì)的含量變化會(huì )隨著(zhù)時(shí)間累積,且積累程度隨著(zhù)NaCl濃度的升高而增加。值得注意的是,羥基四氫嘧啶在0或5% NaCl濃度下很難被合成;而48h后,在10%和15%的NaCl培養基中被檢測到。此外,這兩種物質(zhì)含量均會(huì )隨著(zhù)培養時(shí)間的增長(cháng)而增加。96h后,在15%的NaCl濃度培養下,四氫嘧啶(33.14 mg/g CDW)和羥基四氫嘧啶(1.17 mg/g CDW)達到最高水平。在10%和15%的鹽濃度環(huán)境下,四氫嘧啶的含量要比羥基四氫嘧啶的含量分別高42.6和28.3倍。這些結果表明,四氫嘧啶會(huì )在N. gilvaYIM 90087T的胞內累積。
除此之外,對胞外的四氫嘧啶和羥基四氫嘧啶含量進(jìn)行檢測并發(fā)現大量的四氫嘧啶被釋放到細胞外。96h后,在0、10%和15%的鹽濃度環(huán)境下,分別釋放了89.20%、92.46%、91.99%和71.09%的四氫嘧啶。在10%和15%的鹽濃度環(huán)境下,有99.31%和99.08%的羥基四氫嘧啶被釋放到胞外。在15%的鹽濃度環(huán)境下,四氫嘧啶的轉運能力顯著(zhù)增強,而羥基四氫嘧啶的轉運能力則隨著(zhù)濃度的增加未出現顯著(zhù)變化。此外,研究表明,將四氫嘧啶轉化為羥基四氫嘧啶的能力會(huì )隨著(zhù)鹽濃度的增加而增強,在15%的鹽濃度環(huán)境下,有50%的四氫嘧啶轉化為羥基四氫嘧啶,并在10%和15%的鹽濃度環(huán)境下,四氫嘧啶和羥基四氫嘧啶的胞外含量最高。

圖4、N. gilva?YIM 90087T菌種中四氫嘧啶和羥基四氫嘧啶的產(chǎn)生統計
6、外源四氫嘧啶和羥基四氫嘧啶對N.gilva?YIM 90087T生長(cháng)的影響
在鹽刺激下,添加外源的四氫嘧啶和羥基四氫嘧啶會(huì )促進(jìn)菌種的生長(cháng)速度。在最適宜的鹽濃度環(huán)境下,添加四氫嘧啶和羥基四氫嘧啶會(huì )輕微促進(jìn)OD600值,而在高濃度鹽環(huán)境下,外源物會(huì )顯著(zhù)促進(jìn)OD600值。其中添加外源羥基四氫嘧啶對菌種的生長(cháng)速度促進(jìn)作用優(yōu)于外源四氫嘧啶。
7、大腸桿菌中四氫嘧啶累積
將重組質(zhì)粒轉入大腸桿菌中,發(fā)現在15%的NaCl緩沖液中,四氫嘧啶很難產(chǎn)生,并在0%的緩沖液中檢測到少量四氫嘧啶。在10%和15%的鹽濃度環(huán)境下,四氫嘧啶的合成速率分別在24h和48h中顯著(zhù)下降,其最大合成速率為[0.5 mg (g CDW)?1?h?1],而最終產(chǎn)出[28.85 mg (g CDW)?1]?。
總結
?如果您的項目有任何問(wèn)題,歡迎點(diǎn)擊下方按鈕咨詢(xún)我們,我們將免費為您設計文章方案



京公網(wǎng)安備 11011302003368號